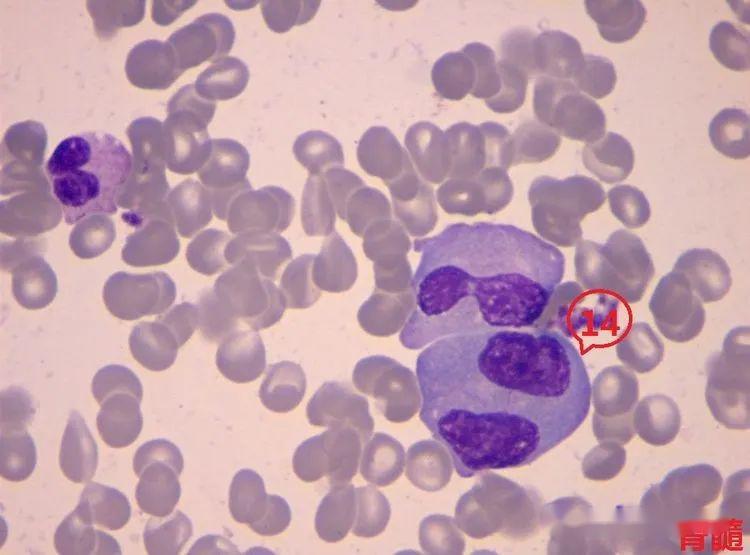
▼「双核骨髓瘤细胞/双核异常浆细胞」形态特征:胞体呈不规则形;胞核

双核细胞

段师形态教学系列(第6期)
图片尺寸1000x1015
接触性出血到底发生了什么病理检查说了算
图片尺寸640x480
血液学细胞形态
图片尺寸1080x845
细胞学分析跑不出这6种情况第5种是肿瘤
图片尺寸456x319
双核浆细胞可见.很少见到双核异型淋巴细胞!
图片尺寸999x1080
【朝华夕秀】看图专栏(第12期)_粒细胞
图片尺寸750x750
▼「双核骨髓瘤细胞/双核异常浆细胞」形态特征:胞体呈不规则形;胞核
图片尺寸750x555
1.超巨早幼红细胞 胞体大,浆灰蓝色,双核,染色质疏 松网状 2.
图片尺寸1137x903
细胞核
图片尺寸1080x810
双核异型细胞(瑞染 高倍镜)
图片尺寸854x640
看图识细胞第78期
图片尺寸750x750
肝硬化双核的再生肝细胞
图片尺寸700x718
小滋养体约为红细胞直径1/6,环纤细,可见"耳麦"样双核,一个红细胞可
图片尺寸800x600
2)放射线损伤后淋巴细胞形态变化:淋巴细胞最敏感:核固缩,核破碎,双核
图片尺寸1024x768
076.「双核淋巴细胞」▼065.「单核细胞」▼054.
图片尺寸1040x770
核质比高且变化不一,细胞核大小不一,细胞双核化,染色质粗糙等
图片尺寸456x317
a. 细胞须为双核.
图片尺寸382x610
(c)偶见双核的浆细胞(箭头所示).
图片尺寸640x427
3,抑制恶性肿瘤细胞转移.
图片尺寸581x364
「(组织细胞样)双核浆细胞」形态特征:胞体巨大,呈不规则形;胞核2个
图片尺寸1040x770